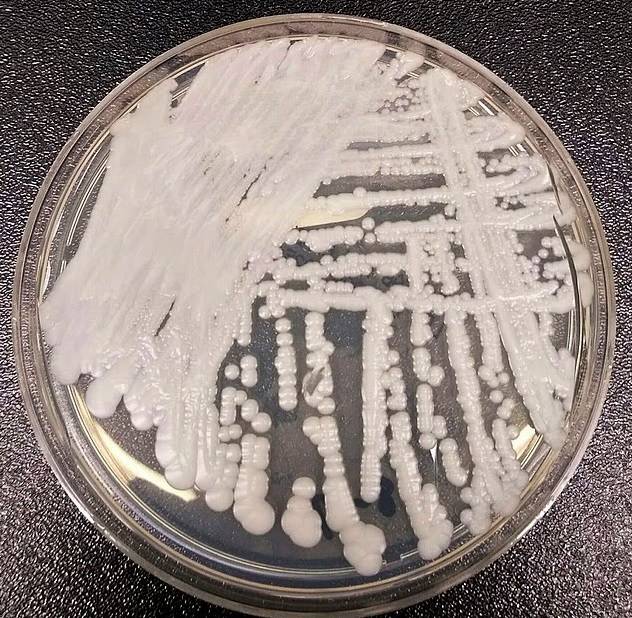
فطر قاتل مقاوم للعلاج ينتشر في مستشفيات أمريكية

منوعات 30 سبتمبر 2025
اختبار جديد يتنبأ بأمراض الكبد القاتلة قبل 10 سنوات
تُعد أمراض الكبد من أخطر المشكلات الصحية، ورغم أن 90% من الحالات يمكن الوقاية منها، فإن غياب التشخيص المبكر يظل العقبة الأكبر. تنبؤ سريع عبر فحص دم بسيط وابتكر العلماء أداة جديدة تُعرف باسم (CORE)، قادرة على التنبؤ بخطر الإصابة بأمراض الكبد الحادة خلال 10 سنوات. وتعتمد الأداة...